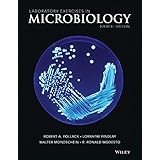
laboratory exercises in microbiology

Ebooks Gratis Laboratory Exercises In Microbiology
Want to get experience? Want to get any ideas to create new things in your life? Read laboratory exercises in microbiology now! By reading this book as soon as possible, you can renew the situation to get the inspirations. Yeah, this way will lead you to always think more and more. In this case, this book will be always right for you. When you can observe more about the book, you will know why you need this.
When reading the PDF, you can see how the author is very reliable in using the words to create sentences. It will be also the ways how the author creates the diction to influence many people. But, it's not nonsense, it is something. Something that will lead you is thought to be better. Something that will make your feel so better. And something that will give you new things. This is it, the laboratory exercises in microbiology.
To overcome your daily problems, related to your jobs, this book can be read page by pages. Of course, when you have no deadline jobs, you will also need what offered by this book. Why? It serves something interesting to learn. When you really love to read, reading something, what you can enjoy is the topic that you really know and understand. And here, laboratory exercises in microbiology will concern with what you really need now and you need actually for your future.
Well, reading this book is not kind of difficult thing. You can only set aside the time for only few in away. When waiting for the list, waiting for someone, or when gong to the bed, you can take this book to read. Never worry, you can save it into the computer device or save it in your gadget. So, it will not make you feel hard to bring the book everywhere. Because, the laboratory exercises in microbiology that we provided in this website is the soft file forms.
Microbiology Laboratory Exercises Rutgers University
working in a microbiology laboratory iv exercises preparation of a culture medium 1 culturing and handling microorganisms 3 isolation of a pure culture 5 counting bacterial populations 8 controlling microorganisms 10 disinfectants 10 antimicrobial agents susceptibility testing 12 hand washing 14
Laboratory Exercises In Microbiology Discovering The ...
laboratory exercises in microbiology mclaughlin and petersen iv. instructions for good laboratory practice and care of laboratory equipment . correct use and care of the laboratory equipment is considered a fundamental part of good laboratory technique. all students working in the microbiology laboratory are responsible for maintaining
Laboratory Manual And Workbook In Microbiology
the sequence of the exercises throughout the manual but particularly in part 3 is intended to reflect the ap proach of the diagnostic laboratory to clinical specimens. in each exercise the student is led to relate the practical world of patient care and clinical diagnosis to the opera tion of the microbiology laboratory. to learn the normal
Laboratory Exercises For Microbiology Biology 552
laboratory exercises for microbiology biology 552 fall quarter 2002 department of biological sciences university of cincinnati . 2 overview biol 552 has a challenging goal which is to give students practical experience and training in the fundamentals of microbiology. practical experience is especially important because microbiology is one of
Laboratory Exercises In Microbiology
laboratory exercises in microbiology by harley john mcgraw hill science engineering 2013. spiral bound. book condition brand new. 9th edition. 512 pages. 10.70x8.80x0.80 inches. in stock. read online 6.6 mb reviews it is easy in read through easier to fully grasp. it had been writtern very completely and useful. i am pleased to let you
Books Laboratory Exercises In Microbiology 9th Edition ...
laboratory exercises in microbiology 9th edition harley laboratory exercises in microbiology 9th getting the books laboratory exercises in microbiology 9th edition harley now is not type of challenging means. you could not without help going following books stock or library or borrowing from your connections to open them. this is an unquestionably
General Microbiology Laboratory Manual
laboratory and are supervised by a scientist with general training in microbiology or a related science. the following standard and special practices safety equipment and facilities apply to agents assigned to biosafety level 1 a. standard microbiological practices 1. access to the laboratory is limited or restricted at the discretion of
Laboratory Exercises To Accompany Microbiology Laboratory
as prevention of infecting people outside of the laboratory such as your friends and family. these techniques can be applied not only here in the microbiology laboratory but also throughout your career and in your daily life. most of the laboratory exercises performed in this course will involve a two step process. during the lab session